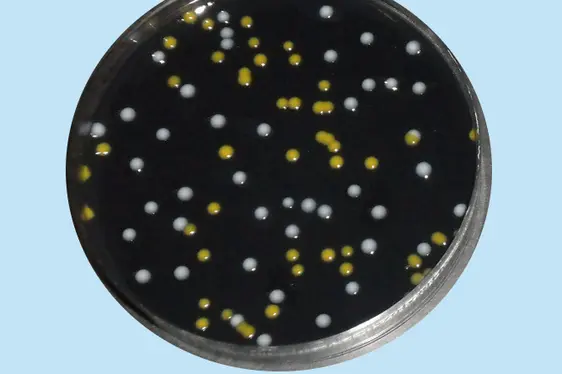
Kolonien von Legionella spp. (weiße Kolonien) auf Selektivnährboden (Foto: Landesagentur für Umwelt und Klimaschutz)

Legionellen
Was sind Legionellen?
Legionellen sind in der Natur weit verbreitete Bakterien. Sie leben in Flüssen, Seen, Thermalquellen, Quellen, natürlichen Wasserbecken und anderen feuchten Lebensräumen. Von dort aus können sie das Wasserverteilernetz von Gebäuden, Klimaanlagen, Schwimmbädern, Brunnen und Kühltürmen besiedeln und dabei zum Gesundheitsproblem werden. Legionellen kommen sowohl freilebend im Wasser als auch in Biofilmen vor. In diesen aus Mikroorganismen (Bakterien, Algen Protozoen, Viren, usw.) gebildeten Schichten finden sie Schutz vor Desinfektionsmitteln, die freilebende Legionellen töten oder deren Wachstum hemmen könnten.
Das Biologische Labor überprüft Wasserproben aus öffentlichen und privaten Wasserleitungen auf das Vorkommen von Legionellen.
Legionellen können sich im Wasserverteilungsnetz rasch vermehren, wenn
- die Wassertemperatur zwischen 20 und 55°C liegt*,
- das Wasser in Leitungen (Totleitungen) und Speichern lange verweilt bzw. stagniert,
- Leitungen oder Speicher entweder mit Biofilmen bewachsen sind oder Kalk bzw. sonstige Ablagerungen vorhanden sind.
* Influence of water temperature on the growth of Legionella in real environmental samples: Surveillance in South Tyrol 2011-2016. Stenico et al. (2017) - Poster präsentiert beim Kongress „The 9th International Conference on Legionella“, Rom 20-26/9/2017
Legionellen sind nur ansteckend, wenn sie eingeatmet werden. Das Trinken von Wasser, das mit Legionellen verunreinigt ist, macht hingegen NICHT KRANK. Legionellen sind außerdem NICHT von Mensch zu Mensch übertragbar.
Die Übertragung von Legionellen und eine mögliche Infektion der Atemwege erfolgt über das Einatmen von mikroskopisch kleinen Wassertropfen, den sogenannten Aerosolen (zerstäubtes Wasser). Bakterienhaltige Wassertröpfchen, wie sie beim Duschen, an Wasserhähnen, in Luftbefeuchtern, Kühltürmen, Klimaanlagen, Whirlpools oder Brunnen entstehen, sind mögliche Quellen einer Ansteckung.
Legionellen können beim Menschen verschiedene Krankheiten hervorrufen, die von einer grippeähnlichen Erkrankung bis hin zu schwerer Lungenentzündung reichen. Eine schlimme Form der Lungenentzündung ist die sogenannte „Legionellose“, die besonders für immungeschwächte Personen gefährlich werden kann. Die meisten Krankheitsfälle werden beim Menschen durch die Art Legionella pneumophila hervorgerufen.
Gesunde Menschen erkranken im Normalfall nicht. Ab welcher Legionellen-Konzentration es zu einer Infektion kommt, ist von Mensch zu Mensch verschieden. Einige Faktoren erhöhen jedoch das Infektionsrisiko:
- männliches Geschlecht
- erhöhtes Alter
- Alkoholkonsum
- Rauchen
- chronische Lungenerkrankungen oder Krankheiten, die zu Immunschwäche führen
- Medikamente zur Unterdrückung des Immunsystems (Immunsuppressiva)
Die Risikobewertung ist ein wichtiges Instrument für das Management des Legionellen-Risikos. Die Betreiber von Strukturen sind für die Risikobewertung und die Durchführung geeigneter Maßnahmen verantwortlich. So schreiben es die 2015 veröffentlichten nationalen Leitlinien für die Vorsorge und Kontrolle von Legionellose sowie das gesetzesvertretende Dekret 81/2008 über die Sicherheit am Arbeitsplatz vor. Die Risikobewertung ist komplex, muss von qualifiziertem Personal durchgeführt werden und beginnt mit der gründlichen Inspektion der Anlage.
Jeder Einzelne kann durch angemessene Verhaltensweisen dazu beitragen, das Legionellen-Risiko im eigenen Haushalt zu senken (siehe unter „Vorsorgemaßnahmen für jedermann“).
Der Betreiber des öffentlichen Wasserversorgungsnetzes gewährleistet die Qualität des gelieferten Wassers bis zum Übergabepunkt (Anschluss an das Kondominium oder an die Wohneinheit). Ab diesem Punkt liegt die Verantwortung für die Wasserqualität beim Kondominiumsverwalter oder beim Immobilieneigentümer.
Um das Legionellose-Risiko gering zu halten, sind in Neubauten sanitärtechnische Anlagen entsprechend den geltenden technischen Normen zu planen. Heute haben Konstrukteure verschiedene Möglichkeiten, die Ausbreitung von Legionellen einzuschränken. Bei Problemen mit Legionellen sind auch bei bereits bestehenden Anlagen technische Lösungen möglich. Eine periodische Wartung trägt dazu bei, das Risiko einer Verseuchung mit Bakterien zu verringern bzw. deren Vermehrung und Verbreitung zu minimieren.
- Regulierung der Kalt- und Warmwassertemperatur:
Warmwasser muss an jedem Punkt (Speicher, Entnahmevorrichtungen, usw.) eine Temperatur von mehr als 55°C aufweisen, Kaltwasser hingegen eine Temperatur von weniger als 20°C. - Wasser an jedem Wasserhahn ein- bis zweimal die Woche laufen lassen, vor allem dort, wo Wasser über längere Zeit in Leitungen staut (nicht oder wenig genutzte Wasserhähne).
- Bei Reparaturen oder Hydraulikerarbeiten darauf achten, keine Wasserstauungen oder Totleitungen zu verursachen.
- Wenn alle Wasserhähne mehr als eine Woche geschlossen bleiben, das Wasser vor Verwendung an jedem Wasserhahn lang laufen lassen.
- Periodische Wartung einer Anlage: Reinigung, Entkalkung, Desinfektion der Entnahmepunkte (Wasserhähne und Duschköpfe), Reinigung und Desinfektion der Filter von Klimaanlagen
- Verschlissene Teile (Duschschläuche, Duschköpfe, Wasserhähne, Dichtungen, Filter, usw.) austauschen
Die mikrobiologische Überwachung ist ein Instrument zur Unterstützung der Risikobewertung.
Die Kalt- und Warmwasser-Beprobung ist sinnvoll, wenn die Wassertemperaturen in der Anlage die Entwicklung von Legionellen begünstigen könnten (Temperaturen über 20°C) oder es Stellen gibt, wo Wasser über längere Zeit liegen bleibt (Totleitungen). In diesem Fall geben die Richtlinien vor, wo die Wasserproben zu entnehmen sind. Im Allgemeinen liefert die Beprobung und Untersuchung an einem einzelnen Punkt keine hilfreichen Informationen. Die mikrobiologische Untersuchung einer Anlage ist nur dann nützlich, wenn verschiedene repräsentative Punkte der Anlage überprüft werden und die mikrobiologischen Untersuchungsergebnisse in Zusammenhang mit Wassertemperatur und Informationen über eventuelle Behandlungen beurteilt werden.
- Die Probennahme von Warmwasser für die mikrobiologische Untersuchung erfolgt an folgenden Stellen:
- am Vorlauf (möglichst nahe am Speicher)
- am Rücklauf
- am Boden des Speichers sowie
- an mindestens drei weiteren repräsentativen Stellen (am weitesten entfernte Stellen oder Stellen mit der tiefsten Wassertemperatur).
- Die Probennahme von Kaltwasser für die mikrobiologische Untersuchung erfolgt an folgenden Stellen:
- am Boden des Speichers sowie
- an mindestens zwei weiteren repräsentativen Stellen (die am weitesten entfernte Stelle sowie jene mit der höchsten Wassertemperatur).
Für die Legionellenuntersuchung muss man einen Liter Wasser in einem sterilen Behälter abfüllen. Um die Exposition am geöffneten Wasserhahn zu beurteilen, wird die Probe unmittelbar nach dem Aufdrehen des Wasserhahns entnommen. Will man hingegen das Leitungssystem auf das Vorkommen von Legionellen kontrollieren, lässt man das Wasser vor der Probenentnahme mindestens fünf Minuten laufen. Die Wasserprobe muss bei Raumtemperatur und vor Licht geschützt gelagert und transportiert werden. Um den Untersuchungsbeginn innerhalb von 24 Stunden nach der Probenentnahme zu gewährleisten, muss die Wasserprobe so schnell wie möglich im Biologischen Labor abgegeben werden.
Bei den Untersuchungsmethoden handelt es sich um genormte Kulturverfahren, die vom italienischen Akkreditierungsinstitut ACCREDIA (Ente Italiano di Accreditamento) anerkannt sind und der europäischen Norm UNI CEI EN ISO/IEC 17025 entsprechen.
Hier finden Sie die Auflistung der von ACCREDIA akkreditierten Untersuchungen.
Rechtsgrundlagen:
- Richtlinien zur Vorsorge und Kontrolle von Legionellose (Linee guida per la prevenzione e il controllo della legionellosi, approvate in Conferenza Stato-Regioni nella seduta del 7 maggio 2015 - Italia)
- Gesetzesvertretendes Dekret vom 23. Februar 2023, Nr.18
- Gesetzesvertretendes Dekret vom 9. April 2008, Nr. 81
- Norm UNI EN 806-2/2008: Specifiche relative gli impianti all’interno di edifici per il convogliamento di acque destinate al consumo umano. Parte 2: Progettazione